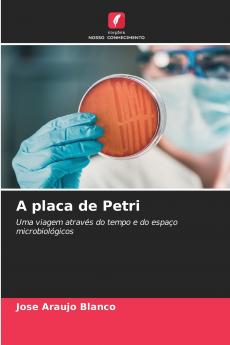
A placa de Petri
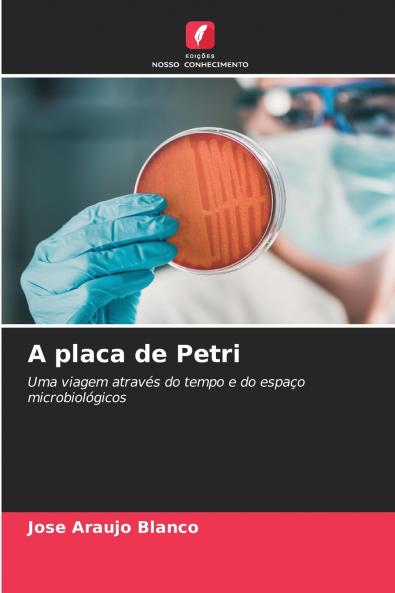
A placa de Petri

Portuguese
Paperback
₹8482
₹11484
26.14% OFF
(All inclusive*)
Delivery Options
Please enter pincode to check delivery time.
*COD & Shipping Charges may apply on certain items.
Review final details at checkout.
Looking to place a bulk order? SUBMIT DETAILS
About The Book
Description
Author
A Placa de Petri: Uma Viagem no Tempo e no Espaço da Microbiologia:Nesta obra exploramos a fascinante história e evolução da placa de Petri um elemento essencial na microbiologia. Desde os seus primórdios detalhados no Capítulo 1 descobrimos as raízes microscópicas e a viagem através do tempo deste dispositivo. Discutimos as primeiras aplicações em microbiologia e bacteriologia que revolucionaram a ciência com esta ferramenta inovadora.No capítulo 2 sobre a era contemporânea analisamos a sua aplicação na indústria alimentar na indústria farmacêutica na ecologia microbiana e na biotecnologia bem como a sua intersecção com a engenharia genética e a bioinformática. Além disso exploramos o seu papel na vigilância epidemiológica e no controlo de doenças bem como o seu impacto na educação e divulgação científicas.Finalmente no capítulo 3 navegamos pelo futuro da placa de Petri. Investigamos as tendências emergentes em termos de tecnologia automação inteligência artificial e novos modelos teóricos. Analisamos os desafios éticos e regulamentares que se colocam à investigação microbiológica futura.
Delivery Options
Please enter pincode to check delivery time.
*COD & Shipping Charges may apply on certain items.
Review final details at checkout.
Details
ISBN 13
9786207929085
Publication Date
-12-08-2024
Pages
-124
Weight
-179 grams
Dimensions
-152x229x7.42 mm